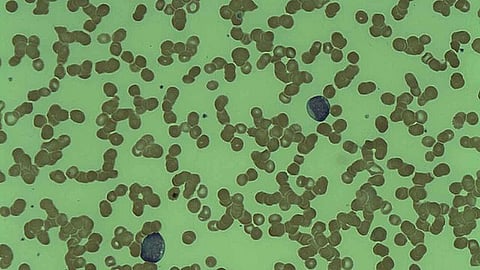
Acute Myeloid Leukemia (Wikimedia commons)

BUFFALO, N.Y. — Up to 30% of patients newly diagnosed with acute myeloid leukemia (AML) have an FLT3 gene mutation, which is associated with a high risk of relapse and a very poor prognosis. But clinical studies have shown that drugs called FLT3 inhibitors can extend long-term survival in these patients, especially when given in combination with other treatments. A phase 2 clinical trial led by Roswell Park Comprehensive Cancer Center tested that strategy for treating FLT3-mutated AML, and the encouraging results are newly reported in the Journal of Clinical Oncology, a journal of the American Society of Clinical Oncology.
Eunice Wang, MD, Chief of Leukemia/Benign Hematology at Roswell Park, and principal investigator of the clinical trial, is first author of the study, “Crenolanib and Intensive Chemotherapy in Adults with Newly Diagnosed FLT3-Mutated Acute Myeloid Leukemia.” Sponsored by Arog Pharmaceuticals, the clinical trial enrolled 44 patients ranging from 19-75 years old who were newly diagnosed with FLT3-mutated AML.
The investigators report that giving the FLT3 inhibitor crenolanib along with intensive chemotherapy resulted in high overall response rates and prolonged event-free and overall survival. Moreover, crenolanib is safe when given continuously with intensive chemotherapy, and after the end of chemotherapy, it does not slow the return of blood cell counts to normal levels.
During the induction phase of chemotherapy — the initial treatment, aimed at inducing remission — patients received “7+3” chemotherapy, a combination of cytarabine and an anthracycline-based drug, either daunorubicin or idarubicin, on days 1-7. During consolidation chemotherapy — the phase designed to “clean up” any residual cancer cells — on days 1-3 they received a higher dose of cytarabine and/or an allogeneic stem cell transplant, which replaces the patient’s diseased bone marrow with hematopoietic stem cells from a healthy donor.
Crenolanib was then administered from day 9 until 72 hours before the start of the next chemotherapy cycle, again after consolidation, and then for 12 months after consolidation or transplant.
The overall response rate was 86%, with 77% of participants achieving complete remission — no evidence of disease. Among patients younger than 60, the response rate was even higher, at 90%; among those over 60, it stood at 80%.
Forty-five months into follow-up, median event-free survival — the length of time following treatment when patients’ disease did not recur or worsen — was 44.7 months. At the same time point, median overall survival had not been reached, because more than half of the participants were still alive. Three years after treatment, 55% of participants were alive, including two-thirds of those 60 and younger.
The study was a collaboration with Memorial Sloan Kettering Cancer Center in New York City; Fred Hutchinson Cancer Center in Seattle, Washington; City of Hope National Medical Center in Duarte, California; the University of Iowa in Iowa City, Iowa; the University of Texas Southwestern Medical Center in Dallas, Texas; Arog Pharmaceuticals of Dallas, Texas; and Dana-Farber Cancer Institute in Boston, Massachusetts.
The investigators are extending their research into this approach to therapy with a randomized phase 3 clinical trial. The study will compare crenolanib plus chemotherapy to midostaurin — a different FLT3 inhibitor — plus chemotherapy. It has a projected enrollment of 510. (SB/Newswise)